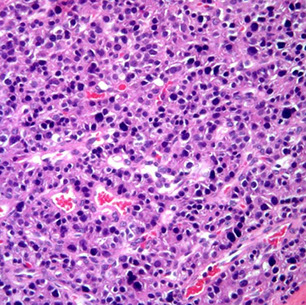

Thyroid
Parathyroid
Thyroid Anatomy, Embryology, Histology
Thyroid hormones (T3/T4)
Melanosis thyroidi
Hyperthyroidism
- Graves' disease
- Thyrotoxicosis
- Toxic Multinodular Goiter
Hypothyroidism
- Thyroid agenesis / dysgenesis
- Dyshormogeneic goiter
- Chronic lymphocytic (autoimmune) thyroiditis [Hashimoto's thyroiditis]
- Cretinism
- Subacute (de Quervain's) thyroiditis
- Lymphocytic subacute (painless) thyroiditis
- Riedel's thyroiditis
Sick Euthyroid Syndrome ("Low T3 Syndrome")
Acute thyroiditis
Familial hypocalcuric hypercalcemia
Sheehan's syndrome
Thyroglossal duct cyst
Heterotopic thyroid tissue
Colloid nodule
Adenomatoid nodule
Follicular adenoma
- Non-invasive Follicular Thyroid Neoplasm with Papillary-like Nuclear Features (NIFTP)
Follicular carcinoma
Insular carcinoma
Hurthle cell adenoma
Hurthle cell carcinoma
Papillary carcinoma
Medullary carcinoma
Undifferentiated / anaplastic
Hyalizing Trabecular tumor
Mammary Analogue Secretory Carcinoma (MASC)
Parathyroid Anatomy, Embryology, Histology
Parathyroid hormone
Primary hyperparathyroidism (parathyroid adenoma)
Secondary hyperparathyroidism (parathyroid hyerplasia)
Hypoparathyroidism
Pseudohypoparathyroidism (Albright's hereditary osteodystrophy)
Parathyroid carcinoma
Thyroid
Thyroid Anatomy
Gr. "shield form" (thyreos eidos), found at C5-T1
- usually 15-25 g
- behind sternothyroid and sternohyoid muscles, broken down into left and right lobes and an isthmus
- blood supply from sup and inf thyroid arteries
-- superior thyroid a. is first branch of external carotid a. and goes to superior poles of thyroid
-- inferior thyroid a. comes from thyrocervical trunk off subclavian a., and go to inferior poles
- thyroid ima artery seen in 1/10, and goes to isthmus
- sup, middle and inf thyroid form thyroid venous plexus
- lymph goes to prelaryngeal, pretracheal and paratracheal LNs, that go to superior cervical and inferior deep cervical LNs
- vasomotor (not secretomotor) nerves derived from sup, middle, and inf cervical ganglia as cardiac, sup and inf periarterial plexus
- up to 10% of the population has a thyroid nodule
Thyroid Embryology
Thyroid analge starts as median endodermal dimple at tongue base in pharyngeal epithelium, starting at foramen cecum and moving down thyroglossal duct (anterior to hyoid bone) by which it remains connected to the tongue
- neural crest cells migrate in and form the parafollicular cells
- cords and plates form @ 9 wks, follicles @10 wks, and colloid @ 12 wks
- pyramidal lobe is thyroglossal duct remnant (in 2/5)
- starts to respond to TSH from pituitary at 22 WGA
- growth mediated by TTF, PAX8 and HHEX
Athyreosis is the complete absence of thyroid glands from developmental failure
- common cause of cretinism (severe MR), which is reversible if caught early
Aberrant (ectopic) thyroid can form from abnormal embryologic migration and can leave thyroid tissue in the base of the tongue, upper neck, or mediastinum
Thyroglossal duct cysts - from remnants of primordial duct along migratory path of the thyroid
- usually in midline of the neck near the hyoid bone
- lined by columnar, cuboidal or squamous cells c mucous glands and occasionally thyroid follicules
Thyroid Histology
Thyroid consists of lots of follicles / acini, which are made of follicular epithelium with follicular cells and scattered (~1/10) C / parafollicular cells and have thyroglobulin-rich colloid in the center and a thin fibrous capsules goes in and breaks the gland into lobules
Follicular cells: low, simple cuboidal (not very active) to columnar (if more active) epithelium c little stroma c lots of vessels
-- activity varies c age (more active the younger)
-- nuclei are small and round c uniform chromatin and tend not to overlap
-- IHC: (+) TTF-1, thyroglobulin
Parafollicular / C cells: derived from neural crest cells and have clear cytoplasm and with small (invisible) granules that secrete calcitonin
-- # C cells decreases c age
-- IHC: (+) TTF-1, neuroendocrine markers, calcitonin, CEA; negative thyroglobulin
"Hurthle" cells / oncocytes / Ashkenzy cells / oxphilic cells are metaplastic follicular cells c red granular cytoplasm (2/2 inc mitochondria)
- dont react as much to thyroglobulin
- can be seen in non-neoplastic (Hashimoto, MNG) or neoplastic (Hurthle cell adenoma / carcinoma) conditions
Follicles are bigger with lots of colloid with dietary iodide deficiency, making the gland hypoactive
- the follicular epithelium is more columnar when active and follicular cells can have colloid droplets inside and form apical pseudopodia c microvilli
Colloid (made of thyrogluobulin, which stores inactive T3 and T4) can look amphophilic or basophilic, this is a normal variant
- other normal variants include: (calcium oxylate) crystals, dystrophic calcifications, adipose metaplasia
Sanderson's Polster are aggregates of small follicles lined by flat epithelium that bulge into the lumen of larger follicles and are assoc c hyperplastic conditions, though this is not the rule
Solid cell nests are remnants of ultimobranchial body (branchial cleft pouches 4-5)
- IHC: (+) CEA, HWMK, LWMK, p63
- ddx: follicular cell metaplasia, nodular C-cell hyperplasia, papillary microcarcinoma
Melanosis thyroidii (aka black thyroid)
- normal variant sometimes seen in thyroids of the elderly, also assoc c chronic minocycline therapy from inc lipofuscin
- colloid usually has birefringent calcium oxalate crystals
-- may be useful to differentiate from parathyroid gland (which has no crystals) for frozen section
Thyroid hormone (T3 / T4)
Made by follicles of thyroid
Function: the B's: Bone growth, Brain maturation, inc B1 receptors in heart, inc Basal metabolic rate, inc Breakdown of substances (inc glycogenolysis, gluconeogenesis, lipolysis)
Regulated by TRH (hypothalamus) which releases TSH from pituitary to work on the follicular cells of thyroid
- T3 has negative feedback on anterior pituitary
Laboratory Evaluation of Thyroid Function
Normal thyroid function
· thyroid regulated by production of TRH in hypothalamus (unregulated) and TSH production in pituitary;
- thyroid hormone affects pituitary responsiveness to TRH. TSH stimulates the complex process of thyroid hormone synthesis as part of the protein thyroglobulin,
which is stored within thyroid follicles (Figure 1). Under
normal circumstances, the thyroid produces primarily T4 (90-95% of total thyroid hormones)
Peripheral fate of thyroid hormones
· Thyroid hormones transported to sites of action by serum proteins (mainly thyroxine binding globulin, or
TBG, with < 30% bound to albumin or transthyretin)
- 99.97% of T4 and 99.7% of T3 is protein bound
- body regulates free thyroid hormones in narrow limits, but does not control total thyroid hormones
-- thus, when TBG gradually increases (or decreases), total thyroid hormone levels change, but altered TSH production maintains free hormone levels at normal levels
· All thyroid hormones are metabolized by removal of a
single iodine group at a time; thus, T4 is converted
primarily to T3, the major active thyroid hormone,
mainly in the liver and kidneys (as well as many other
cells)
-- enzyme catalyzing this reaction is extremely labile; its levels fall with acute illness, with increasing age and are low in neonates. In contrast, the enzyme in
the pituitary is not labile (its activity goes up in acute
illness), so it responds to changes in either T3 or T4
concentration. Another enzyme removes iodine from
the other ring, producing the biochemically inactive
reverse T3 (rT3). In acute illness, these changes in
enzyme activity lead to decreased T3, increased rT3 and no change in TSH; collectively they are referred to as the “euthyroid sick syndrome" or, more recently,
“nonthyroidal illness”.







Black thyroid with calcium oxalate crystals from chronic minocycline therapy









What laboratory tests should be used to evaluate thyroid function?
TSH levels are the most useful test of thyroid status
- log-linear relationship bwt TSH and thyroid hormone levels
-- small change in hormone production leads to much greater changes in TSH, allowing earlier detection of disease. Individuals maintain thyroid hormone levels within narrow limits; a small change in hormone production, enough to alter TSH production, may not cause thyroid hormone levels to move outside the reference interval, while TSH is clearly abnormal. TSH assays have been reported in “generations,” each of which adds a 10-fold increase in lower detection limit (sometimes termed functional sensitivity, the level at which CV is 20%)
- Older textbooks discuss TRH stimulation tests, in which the response of TSH to a bolus of TRH is measured; third generation assays essentially eliminate need for this test, and TRH is not commercially available in the US. Normal individuals will show a 3-5x increase in TSH,while hyperthyroid patients have no response and hypothyroid patients show an exaggerated response. Even in pituitary disease, where a blunted response is expected, almost 75% of patients have a normal or exaggerated response.
Assays for thyroid hormones – Until recently, virtually all assays measured total thyroid hormone; in order to interpret total hormone levels outside the central 75% of the reference range, it is necessary to estimate the amount of TBG. The most common means of doing this is by utilizing the most confusing laboratory test yet devised: the T3 resin uptake. A newer test, termed T-uptake, actually measures thyroid hormone uptake by TBG; this gives results that are the opposite of those seen using T3RU assays.
Evaluation of free thyroid hormone levels
Immunoassays that “measure” free T4 have become the major test of thyroid hormone production. They may give misleading results in pregnancy and in persons with acute illness; the nature of the measurement error depends on the method. The “gold standard” test, equilibrium dialysis, and labeled antibody methods tend to be falsely high in acute illness and falsely low in pregnancy, while two-step (immune extraction) and older analog methods (no longer widely used) give falsely low results in both conditions (although not as abnormal as the other two methods in pregnancy)
Antithyroid antibodies react with one of several thyroid cell components; they are important because most thyroid dysfunction is due to immunologic damage to the thyroid gland
- MC is anti-microsomal or antithyroid peroxidase (anti-TPO) antibodies; high titers are characteristic of Hashimoto's thyroiditis and Graves’ disease. TSH receptor antibodies are found in most patients with Graves' disease. The most specific form of TSH is that which stimulates cyclic AMP production (thyroid-stimulating immunoglobulins, TSI)
- Thyroglobulin (Tg) released in relative proportion to the mass of thyroid tissue or with thyroid injury. Increased levels are commonly seen with thyroid hyperplasia, thyroid tumors and thyroiditis. After thyroidectomy, Tg can be used as a tumor marker for differentiated thyroid cancer (papillary and follicular); levels following resection and radioiodine ablation of thyroid remanants should be undetectable. Anti-Tg antibodies are usually checked when Tg is ordered, since they may cause erroneous Tg results by immunoassay; a fall in anti-Tg indicates no residual thyroid tissue (including carcinoma).


Hyperthyroidism
Hyperthyroidism almost always caused by dz in thyroid gland itself
- low TSH is the single best test for detection of hyperthyroidism.
- If TSH is below detection limits, free T4 and T3 should be measured or estimated
-- free T3 is more sensitive in Graves disease, while free T4 is normal in about 10-15% of patients.
-- In some pts, T4 inc but T3 normal; this occurs if conversion of T4 to T3 is blocked (in older individuals, coexistent severe disease, iodine excess and iodinecontaining drugs)
- Suppressed TSH c normal free T4 and T3 is subclinical hyperthyroidism, assoc c inc risk of cardiac arrhythmias
- MCC hyperthyroidism = Graves' dz, causing diffusely enlarged gland and high radioactive iodine uptake (RAIU)
- Less commonly, hyperthyroidism is result of autonomously functioning thyroid nodule, or may occur transiently in thyroiditis
- In equivocal cases, measurement of TSH receptor antibodies (particularly TSI) used to help in the DDx
- In pregnant patients with Graves' disease, the degree of elevation of TSI correlates with the severity of goiter (and hyperthyroidism) in the infant
2 flavors: 1) Graves disease, 2) Toxic multinodular goiter
1) Graves' disease
aka diffuse toxic hyperplasia
MCC endogenous hyperthyroidism (~85%)
Sx: Triad of hyperthyroidism, ophthalmopathy (proptosis from inc glycosaminoglycans) and pretibial myxedema
Mech: Autoimmune antibody stim of TSH receptors (assoc c HLA D3 and B8 T-cells) usually in women
- considered a Type II HS, no immune complexes in blood
- Thyroid Stimulating Immunoglobulins (TSI) predominates over Thyroid Growth Igs (TGI)
- may see anti-TG and anti-TPO, which are also in Hashimoto's
Gross: gland symetrically enlarged, red, c meaty cut surface
Can also see diffuse goiter: enlarged thyroid caused by inc stim of TSH receptors resulting in hyperplasia, which is seen in Graves' dz and iodine deficiency (pts c iodine deficiency usually euthyroid, though can become hyperthyroidic)
Inc SNS activity leads to overstim of levator palpebra superioris which leads to a wide-eyed lid lag
Micro: 1) Diffuse hypertrophy / hyperplasia of tall columnar follicular cells; 2) moth-eaten colloid; 3) lymphocytic infiltrate
- may have papillary architecture, but do NOT confuse c papillary carcinoma!!!
- hyperplastic follicles can be seen in sk muscle
Imaging: Diffuse uptake throughout entire gland
Tx: radioactive iodine; steroids for ophthalmopathy; propanolol
- radioactive iodine contraindicated in pregnancy and with severe ophthalmopathy
Thyrotoxicosis
- aka the thyroid storm!
Stress-induced catecholamine surge that can lead to death from arrhythmia
- a serious complication of Gaves' and other hyperthyroid disorders
Jod-Basedow phenomenon
Pt gets contrast dye for imaging which leads to hyper(para?)thyroidism
- thyrotoxicosis if an iron-deficient pt gets a bunch of iron for studies
Labs: inc Ca2+, inc glucose, inc LDL-R --> dec cholesterol
Tx: Propranolol (B-blocker), PTU / methimazole, iodinated contrast material (to block T4-T3 conversion); Radioablation
2) Toxic multinodular goiter (TMG)
- toxic = hyperfunctioning
Focal patches of hyperfunctioning follicular cells that work independent of TSH 2/2 TSH-R maturation
- inc release of T4 and T3, though patient is usually euthyroid
- nodules are not malignant, and come in variety of sizes, could be the largest of all goiters
Gross: some nodules tan and gelatinous with lots of colloid, others cystic and focally calcified, c fresh or old bleeding
Micro: similar to gross, is variegated with micro and macro follicles, bleeding, fibrosis and calcs, cholesterol crystals, and areas c adenomatous proliferation and hyperplasia
Imaging: 131-I uptake is uneven c "hot-spots"
Hypothyroidism
Hypothyroidism is at least as frequent as hyperthyroidism and is even more common in the elderly.
- single best test for hypothyroidism is TSH, which is inc even in very mild hypothyroidism.
- a significant number of pts who have "subclinical hypothyroidism," with normal free T4 and elevated TSH; ~1/2 progress to clinical hypothyroidism.
-- likelihood of progression greater c higher TSH ( > 20 mU/L) or high titer of anti-TPO
-- T3 falls in many situations and are normal in 40% of hypothyroid individuals; T3 is thus not a useful test for hyopthyroidism
- In secondary hypothyroidism, TSH is dec in ~1/2 of cases, normal in ~2/5, and slightly inc in ~1/10
Thyroid agenesis / dysgenesis
#1 cause of congenital hypothyroidism
Dyshormogenetic goiter
#2 cause of congenital hypothyroidism
Chronic lymphocytic (autoimmune) thyroiditis
- aka Hashimoto's thyroiditis (HT)
MCC hypothyroidism and thyroiditis; almost exclusively in perimenopausal women
- autoimmune dz (antithyroid and antimicrosomal antibodies) where follicles destroyed by T cells (CD4+ T cell activation c formation of cytotoxic CD8+ cells), causing pt to become hypothyroid
- grossly enlarged, symmetrical
Gross: pale-white, rubbery thyroid
anti-TSH-R ab's made by germinal center B cells
- antimicrosomal and antithyroglobulin abs
- HLA-DR5 assoc
Thyroid cell death from 1) TH1 cells, 2) IFN-gamma secreted by TH1 cells activates macrophages, 3) ab's cause ADCC
Micro: lymphocytic infiltrate c germinal center and plasma cells; Hurthle cells (enlarged epithelial cells c eosinophilic granular cytoplasm)
- extensive oncocytic change
Tx: levothyroxine (for life); surgery if does not regress
Px: inc risk autoimmune dz and B-cell non-Hodgkin lymphoma (usually B-cell [DLBCL], extranodal marginal zone B-cell lymphoma (MZL) and mixed DLBCL / MZL), papillary ca and Hurthle cell neoplasms
- can possibly lead to atrophy of thyroid
Cretinism
Severe fetal hypothyroidism in areas where iodine deficient (China)
*** Cold, constipated babies***
- may be defect in T4 formation or lack of thyroid development
Sx: Pot-bellied, puffy-faced child c protruding umbilicus and protuberant tongue, which later have short stature and mental retardation
Subacute thyroiditis
- aka de Quervain's thyroiditis or granulomatous thyroiditis
Flu-like viral URI (ie mumps or coxsackie virus) causes a self-limiting hypothyroidism, which may start out hyperthyroid
- macrophage presents ag c HLA-B35 to stimulate Tc cells
- 3 F > 1 M
Sx: Very painful thyroid gland, with fever but without lymphadenopathy, jaw pain
Labs: inc ESR
Micro: granulomatous inflam around follicles, MNGCs engulf colloid, caseating necrosis absent
IHC: CA19-9 strongly (+) in late stage, CEA (+) in center of granuloma
Tx: ASA, resolves in a few weeks
Lymphocytic subacute (painless) thyroiditis
Painless thyroiditis; uncommon; goitrous thyroid enlargment; sometimes in post-partum women
- pt at risk to become hypothyroid w/in 10 yrs
Micro: lymphocytic thyroid infiltration, without fibrosis or Hurthle cell metaplasia
Riedel thyroiditis
Rare form of inflammatory fibrosclerosis c mediastinal fibrorosis, sclerosing cholangitis and inflammatory pseudotuor of orbit, Rock-hard thyroid caused by replacement of normal thyroid tissue by fibrous tissue; 3F>1M
- since not as much normal thyroid tissue, pt becomes hypothyroid
- sticks to neck structures
- may be assoc c idiopathic fibrosis in other parts (such as the retroperitoneum)
*** Reidel's rock-hard fibrils ***
Sx: painless goiter
Micro: macros and eos infiltrating
Tx: difficult to excise bc no plane of cleavage
Sick Euthyroid Syndrome ("Low T3 Syndrome")
- aka non-thyroidal illness, NTI
Acutely sick pt, hospitalized for whatever reason, has coincidental lab findings of Low T3, Normal T4 and Normal TSH
Increased TBG is caused by active liver injury, pregnancy, and many drugs; MC are estrogen, estrogen dominant oral contraceptives, phenothiazines and opiates
Decreased TBG is less common, occurring with protein losing states, cirrhosis and occasionally due to congenital deficiency. Patients with TBG abnormalities can be recognized by the reciprocal changes in T4 and T3RU and normal TSH
- thought to be 2/2 caloric deprivation and inc cytokines (IL1, IL6)
it is therefore not advised to do thyroid tests on recovering pts (unless you are really looking for hyper-/hypothyroidism
Subclinical primary hypothyoidism
inc TSH, normal T4 and T3
Acute thyroiditis
Sx: Painful thyroid and painful lymphadenopathy
- initial thyrotoxicosis c inc T4, dec TSH, dec iodine uptake on imagine
- usually bacterial (Strep hemolyticus, Staph aureus) or CMV in AIDS pts
Histo: Thyroid gland destruction (necrosis) c acute inflam
Tx: Abx (usually has bacterial etiology)
Familial hypocalcuric hypercalcemia
- aka benign familial hypercalcemia
AD, isolated hypercalcemia, with normal parathyroid glands and normal serum parathyroid hormone levels
Sheehan's syndrome
Pituitary becomes enlarged during pregnancy 2/2 in prod of lactotrophs, but the blood supply does not inc; therefore during the blood loss and stress of childbirth the pituitary gland can infarct leading to a secondary postpartum hypopituitarism
Sx: fatigue, anorexia, poor lactation, loss of pubic and axillary hair
Thyroglossal Duct Cyst
Thyroglossal duct cysts - from remnants of primordial duct along migratory path of the thyroid
- usually in midline of the neck near the hyoid bone
- lined by columnar, cuboidal or squamous cells c mucous glands and occasionally thyroid follicules
- moves c deglutition
Tx: Sistrunk procedure (need mid-3rd of hyoid bc thyroid passes through there and can get recurrences otherwise)
Heterotopic Thyroid Tissue
MC location: base of tongue, but also in tongue, submandibular area, larynx, lymph nodes and even heart
Struma ovarii
Colloid nodule
Hyperplastic nodule c big distended follicules
- area of colloid is much greater than the area occupied by the follicular cells
Adenomatoid nodule
Hyperplastic lesion c some features of adenoma
Thyroglossal duct cyst



Toxic Multinodular Goiter (TMG)


Multinodular Goiter


TMG: asymmetric enlargement, multinodular, hemorrhage, calcs, fibrosis, cystic degeneration





Grave's disease




Graves dz, c prominent infolding of hyperplastic follicular epithelium

Cretinism
Subacute thyroiditis




Riedel thyroiditis

Sheehan syndrome
Follicular adenoma
MC type of adenoma; solitary well-encapsulated nodule made of small follicles c round nuclei that look like normal follicular epithelium and has little colloid in the middle of each microfollicle
- normal thyroid surrounding the nodule is usually compressed
- entire capsule must be examined, for if there is an area of invasion into the capsule, must dx folicular carcinoma
Comes in several flavors:
- Embryonal (microfollicular) - cellular cords w/o distinct follicles, colloid usually absent
- fetal (microfollicular) - small follicles with small amts of colloid
- simple: regular sized follicles
- colloid (macrofollicular) - large follicles with abundant colloid
- Hurthle cell: rare, large acidophilic cells, cytoplasm teeming c mitochondria
Follicular adenoma


Non-invasive Follicular Thyroid Neoplasm with Papillary-like Nuclear features (NIFTP)
- used to be known as noninvasive encapsulated follicular variant of papillary thyroid carcinoma (EFVPTC or NVPTC)
-- Much taken from : http://www.pathologyoutlines.com/topic/thyroidglandNIFTP.html
Follicular variant of PTC if non-invasive, has nuclear features of PTC but is well-circumscribed (to make definitive dx must be excised and not show invasion)
- should be able to distinguish from b9 hyperplastic nodules and follicular adenoma
Inclusion criteria:
Major Criteria
1) encapsulation or clear demarcation
2) follicular growth pattern c <1% papillae
3) Solid, trabecular and insular patterns should account for <30% of total tumor volume
4) No psammoma bodies
5) PTC nuclear features (enlargement, crowding/overlap, elongation, irreg contours, grooves, pseudoinclusions, chromatin clearing) with nuclear score of 2-3
Minor Criteria
Dark colloid; irreg shaped follicle, "sprinkling sign", follicles cleft from stroma; MNGCs in follicules
Exclusion Criteria
1) Any capsular / vascular invasion -- if cannot eval whole capsule CANNOT dx NIFTP, must call EFVPTC
2) True papillae that are >1% of tumor vol., psammoma bodies or infiltrative border
3) Tumor necrosis (not assoc c FNA), inc mits (3+/HPF)
4) cell features of other PTC variants (tall cell, columnar cell, cribriform morular)
5) No papillae (?)
6) No BRAF V600E mutations or TERT promoter mutations
Imaging: wider than tall, smooth borders, occurs in multinodular glands, no calcs
- perinodular and intranodular Doppler flow patterns
Cytology: FNA samples usually hypercellular c neoplastic cells possibly c focal nuclear features of PTC in microfollicles
- nuclear features are more subtle than conventional PTC, nuclear inclusions infreq/absent, papillae absent
- colloid may be present
- cannot distinguish NIFTP from invasive encapsulated follicular variant of PTC on FNA
Genes: assoc c RAS mutations, NIFTP somewhere between a follicular adnoma and follicular ca or invasive EFVPTC
- in the RAS spectrum are PAX8/PPARG and THADA fusions, and EIF1AX and BRAF K601E
- should NOT have RET/PTC or BRAF V600E
Tx: can be successfully tx;d c excision(lobectomy)
- subsequent radioiodine not needed
Px: indolent, not really considered a cancer
NIFTP


Figure 3 (a) NIFTP often demonstrates microfollicles intercalating between attenuated larger follicles as seen here in this encapsulated tumor. Inset—diagnostic nuclear features are more common in microfollicular areas. (b) NIFTP also frequently shows accentuation of nuclear features at the periphery, as evidenced by the paler appearance at low-power magnification. Inset—the periphery demonstrates readily visible diagnostic nuclear features. In both insets, the nuclear features are not as prominent as commonly seen in classic papillary
thyroid carcinoma [2]

minimally invasive follicular ca


Lymphovascular invasion - minimally invasive follicular ca
Follicular Carcinoma
2nd MCC thyroid ca (10-20%)
- usually in older women and solitary
Inc incidence in areas c iodine deficiency, thus may be related to nodular goiter
Imaging: appear cold on scintigrams (though can be warm if hyperfunctioning)
Gross: can be well-defined or highly infiltrative and can penetrate capsule
- thryoid capsule or the capsule surrounding the tumor should be extensively sampled in order to judge if cancer is a minimally invasive follicular carcinoma
-- presence of LVI should be determined in vessels within or outside of the capsule, as the presence of LVI within the tumor is not significant
2 types of tumors: widely invasive and minimally invasive
- minimally invasive tumors indistinguishable from follicular adenoma grossly, except that the capsules of follicular carcinoma are thicker and more irregular
- widely invasive follicular ca can have extensive permeation of capsule grossly
Micro: uniform follicules c colloid (like normal thyroid); cannot differentiate a follicular carcinoma from a follicular adenoma based purely on cytology, but need to see an invasive component (in or through capsule or vascular invasion) or distant mets
- look out for vascular invasion (in our outside of capsule) that is attached to the BV wall
-- tumors plugging the BV may become endothelialized
- nuclei lack features of papillary ca, and psammoma bodies are not present
- variant c granular eosinophilic cytoplasm (Hurthle cells), dubbed oncocytic variant
- may see atypia and necrosis, but these by themselves are not sufficient for dx of carcinoma (must have capsular invasion!!!)
IHC: (+) TTF-1, thyroglobulin, PAX8, CAM5.2, AE1/3
Genetics: 40% assoc c RAS mutation (as in follicular adenoma), 30% c PAX8/PPARgamma translocation t(2;3)9q13;p25)
Tx: total thyroidectomy c radioactive iodine (mets take up the iodine and can be hunted down and terminated)
Px: Intermediate aggressiveness with hematogenous spread, but dependent on extent of invasion / stage
- minimally invasive has excellent px, widely invasive has poor px
- Hurthle cell (oncocytic) lesions and tumors > 4-6 cm more likely to involve an ipsilateral LN and to met, and have tendency to recur in neck and cause death
-- tumors <2 cm almost always adenoma
- mets are usually through the blood
Insular carcinoma
Poorly differentiated carcinoma that grows in sheets, ribbons and cords c nuclei that look like follicular ca (not very pleomorphic)
- commonly has mits, necrosis, infiltration, and vascular invasion
Insular carcinoma


Hurthle cell adenoma
Similar appearance as follicular adenoma, but with Hurthle cell (oncocytic) changes
- can have prominent nucleoli and slightly pleomorphic nuclei as well
Hurthle cell carcinoma
Rare,variant of follicular ca, same cellular changes as in Hurthle cell adenoma, but with capsular invasion
- cells are eosinophilic due to abundant mitochondria
Px: Intermediate
Hurthle cell carcinoma

Papillary carcinoma (PTC)
MCC (80%) thyroid ca; excellent prognosis
- inc risk c childhood irradiation
- may arise from lymphocytic (Hashimoto) thyroiditis
- can be multicentric
Risk of having papillary microcarcinoma inc c age, and is B9, nothing to worry about
Micro: Ground-glass (Orphan Annie) nuclei, psammoma bodies, nuclear grooves (coffee bean), nuclear overlapping and pleomorphism and pseudoinclusions
- no prominent nucleoli
- Cave canum! fixation can produce Orphan-Annie nuclei
Variants:
- based on differentiation: well differentiated (classical, encapsulated, follicular, cystic and microscopic), intermediate differentiated (tall cell, columnar cell, diffuse sclerosing, oncocytic and insular) and poorly diff (presence of tumor necrosis and inc mitoses)
- Papillary microcarcinoma - <1 cm, considered clinically b9
-
Follicular
variant
- has follicular architecture (no papillae)but the nuclei of a papillary neoplasm
- 2 forms of follicular variant: encapsulated / well-circumscribed (excellent px) and infiltrative forms
Aggressive variants
- Diffuse sclerosing - rare; poor px; widely infiltrative c lots of sclerosis and sq metaplasia
- Columnar cell
- Hurthle cell
- Tall cell
- Hobnail
IHC: (+) TTF-1, thyroglobulin, PAX8, CAM5.2, CK19, AE1/3, HBME-1
Genetics: BRAF/RAS mutation or RET/PTC rearrangement in 7/10[1]; possibly APC or PTEN or NTRK1
- cause unregulated MAPK stimulation
- nearly all c RAS mutation have follicular architecture
Lab: inc thyroglobulin
Px Indolent growth, px is good
- Lymphatic spread


Papillary ca - psammoma body and Orphan Annie nuclei
Papillary ca - papillary architecture and nuclear grooves
Encapsulated follicular variant of papillary thyroid carcinoma, including cellular enlargement, nuclear enlargement, and elongation, nuclear overlapping and crowding, optical clearing, nuclear grooves, contour irregularities, and delicate chromatic, also with hypereosinophilic scalloped colloid and crystalloids

Invasive Encapsulated Follicular Variant of PTC (IE-PTC-FV)
Histologically and genetically similar to NIFTP, with follicular growth, papillary-like nuclei, and RAS mutations, but demonstrate either capsular, vascular, or intrathyroidal invasion which precludes the dx of NIFTP
Px: assoc c more aggresssive behavior c capacity for hematogeouns mets similar to follicular carcinoma
Papillary Thyroid Carcinoma with Extensive FOllicular Growth (PTC-EFG)
- AKA infiltrative follicular variant of PTC, or PTC with prominent follicular architecture
Micro: Predominantly follicular architecture, infiltrative growth similar to classic PTC and lymphoatic mets
- may have focal papillar and usually demonstrate intranuclear pseuodinclusions
Genes: like classic PTCs, have been observed to have high frequency of BRAFV600E mutations
- do not have RAS mutations
Cribriform-morular thyroid carcinoma (CMTC)
rare type of thyroid carcinoma, accounting
for fewer than 0.2% of thyroid carcinoma cases.
- F>M, patients under 40 years of age
- can occur sporadically, but a high proportion of CMTC are associated with familial
adenomatous polyposis (FAP). When associated with FAP, they present at a younger age, are usually multifocal and/or bilateral, and occur almost exclusively in females.
- The high association with FAP is due to a similar pathogenesis involving mutations in the APC gene or other Wnt/beta-catenin pathway alterations.
- Until recently, CMTC was considered a subtype of papillary thyroid carcinoma, but studies on pathogenesis and genetics have demonstrated its distinct nature and it is a separate entity in the fifth edition of the WHO classification.
Gross: CMTC can appear as a circumscribed, solid, and white-tan lesion.
Micro: Various growth patterns may be observed, including cribriform, papillary, follicular, and solid.
Areas of papillary or pseudopapillary growth can be lined by tall or columnar cells.
- The neoplastic cells demonstrate nuclei with occasional nuclear clearing, pseudoinclusions, and nuclear grooves. Anastomosing arches can be seen between the cribriform/follicular structures, as seen in this case.
- A characteristic histologic feature of this entity is the presence of squamoid morules, which are small
collections of squamoid cells without keratinization arranged in a whorling pattern.
- Lymphovascular invasion is frequently seen.
IHC: (+) nuclear B-catenin, ER, PR, TTF1, PAX8 (weak), CK AE1/3
- squamoid morules (+) CD5, CDX2, CD10, and are negative for TTF1, PAX8, and ER
Genes: not reqd for dx, but may be useful to test for APC to see if APC
CMTC with squamoid morules

cmtc was considered a subtype of ptc due to similarity of nuclear features

Medullary Carcinoma
1/20 thyroid cancers, may be inherited as autosomal dominant, derived from parafollicular C cells
- produces calcitonin
Gross: solid, yellow-white, usually bilateral
- may resemble brain
- 1/2 c lymph node mets at presentation
Micro: Sheets of cells in amyloid stroma
- cells can be epithelioid or spindly and growing in nests or sheets; appearance of cells is variable
- Salt n peppa nuclei
IHC: (+) calcitonin, TTF-1, Cam5.2, AE1/AE3, mCEA, SYN, CHR, CD56, amyloid deposits Congo red +
- negative thyroglobulin, PAX8 (var)
Genetics: assoc c MEN 2A and 2B, esp if background C cell hyperplasia
*** MC 2 MEN***
- germline point mutations of RET proto-oncogene
Sipple syndrome - assoc c medullary thyroid ca and pheochromocytome
- Familial MTC with C cell hyperplasia
EM: neurosecretory granules in tumor cells
Px: MEN2B assoc tumors c poor outcome
- MEN2A and sporadic tumor intermed aggressive
- non-MEN tumors are indolent (?)
Medullary carcinoma

Medullary ca c amyloid stroma


Medullary carcinoma
Undifferentiated / anaplastic Thyroid Carcinoma
Seen in older pts; least common type of thyroid ca (<5%), usually in elderly women (F>M, 4:1)
Rare, one of the most lethal of all cancers causing 1/2 of all thyroid ca-related deaths but accounting for <5% of thyroid tumors
- rapidly growing mass causing hoarseness that spreads to adjacent structures by dx
- 1/3 arise from pre-existing cancer (ie papillary ca), thus these cancers may be a dedifferentiation of a preexisting differentiated thyroid ca
Gross: large, bulky, bilateral, invasive, rapidly growing; bull-neck appearance
IHC: (+) PAX8 (var), Cam5.2, AE1/AE3,
- neg: TTF-1, thyroglobulin
Genes: P53 mutation
Px: very poor
Hyalizing trabecular tumor
Variant of papillary ca
Predominant trabecular arrangement of tumor cells, separated from each other by a hyalinized stroma rich in blood vessels.
- Tumor cells are large oval to elongated in shape with round to oval mildly pleomorphic nuclei, pale granular chromatin, occasional small distinct nucleoli and abundant pink granular cytoplasm with indistinct cell borders
- nuclear molding due to lysosomes (?)
Called carcinoma if there is capsular or vascular invasion
Genes: RET/PTC gene rearrangement


Hyalizing Trabecular Tumor
Spindle Epithelial Tumor with Thymus-Like Differentiation (SETTLE) of thyroid gland
Rare; indolent tumor of neck in young pts (median 15 yo) c thymic or branchial pouch diff and delayed (after 5 years) mets to LNs or lungs
Micro: invasive, highly cellular tumor c sclerotic bands (thick and thin)
- biphasic c bland spindle cells in fascicles and tubulopapillary epithelial structures or mucinous glands
-- may have foci of squamous diff resembling Hassall's corpuscles
- can have rare mits or focal necrosis
IHC: (+) HMWK (in spindle and epithelioid cells), vimentin (focal), alpha smooth muscle actin, muscle specific actin
- neg: CD3/5/20, Tdt, TMA, calcitonin, desmin, thyroglobulin, S100
SETTLE of thyroid gland

Mammary Analogue Secretory Carcinoma (MASC)
Similar to that seen in salivary gland
Genes: (+) ETV6-NTRK3
MASC

Parathyroid
Parathyroid Anatomy
Parathyroids usually on posterior gland surface
- usually supplied by inf thyroid a., and drained by parathyroid veins into thyroid venous plexus
- lymph drains c thyroid gland
Usually weigh about 30-40 mgs for the 4 glands
- no individual gland should weigh >60 mg
- usually ~1/2 cm flat brown disks
- fat inc c age


Parathyroid Embryology
Parathyroids derived from 3rd and 4th branchial pouches (3rd inf and 4th sup parathyroids)
- may form accessory parathyroids if fragment during separation
Parathyroid from brancial pouch IV do not migrate far and become the superior parathyroids
- Parathyroid from brancial pouch III migrate with the thymus (also from branchial pouch III) and become the lower parathyroids and are more variable in their location
Damage to cr 22 can cause branchial pouches III and IV to fail to form (diGeorge syndrome)
- has loss of parathyroids and thymus
- have marked deficiency in cellular immunity
Ectopic parathyroids somewhat common from branchial pouch III
- glands can be found in the lower neck or mediastinum
- parathyroid cysts can rarely form in the neck and cause a mass (aspiration reveals clear fluid)

Parathyroid histology
Chief / principal cells and oxyphil / acidophil cells in cords or follicular clusters
- also water-clear cells and adipocytes
Chief cells contain parathyroid hormone and can have glycogen inclusions
- scant pale pink cytoplasm c glycogen and neural lipid
Oxyphil / acidophilic cells have lots o mitochondria and may be a form of chief cells
Water-clear cells c hyperchromatic vacuolated nucleus, abundant glycogen c clear cytoplasm
- inc water-clear cells assoc c inc secretory activity
Adipocytes inc c age (up to 1/2 of mass of parathyroids)
Parathyroid hormone (PTH)
Made by chief cells of parathyroid
Functions:
1) inc bone resorption (Ca2+ and PO4-
2) inc kidney resorption of Ca2+ in DCT
3) dec kidney resorption of PO4-
4) inc 1,25- (OH)2 vit D production by stim kidney 1a-hydroxylase
Regulation: dec free serum Ca2+ and Mg2+ inc and dec secretion, respectively
Primary hyperparathyroidism
- Parathyroid adenoma
*** Stones, bones, groans, moans ***
Kidney stones - calcium phosphate
Nephrocalcinosis - Ca2+ deposits in renal interstitium
Generalized osteitis fibrosa cystica, or von Recklinghausen dz of bone
- get inc osteoclastic bone resorption
- marrow replaced by fibrous tissue
- vertebrae, long bones, mandible and hand bones most affected
- x-ray shows expansile cyst, known as a brown tumor
- micro: bone replaced by fibrous tissue, capillaries, MNGCs, hemorrhage, hemosiderophages (cause the brown color), and foamy macrophages
- can resemble giant cell tumor of the bone
- can have salt and pepper appearance on skull x-ray
Chondrocalcinosis (pseudogout, CPPD deposition)
Peptic ulcers and pancreatitis
CNS depression
Up to 95% caused by solitary adenoma, hyperplasia in up to 10% (assoc c MEN 1/2A) or carcinoma (<1%)
- one parathyroid gland is usually enlarged and the rest are diffucult to find
Sx: often asymptomatic, though can the above
Histo: Normal rim of tissue usually present around a parathyroid adenoma
- multiple adenomas are possible but less common than a single adenoma (thus if 1 gland is enlarged on RFS c little fat [<50%, questionable]and rim of normal tissue, may suggest parathyroid adenoma, BUT...)
- since differentiating bwt adenoma and hyperplasia NOT possible on RFS, best to dx "enlarged parathyroid gland" (done by weight)
Labs: Hypercalcemia, hypercalciuria (causes renal stones), hypophosphatemia, inc PTH, inc alk phos, inc cAMP in urine
IHC: Cyclin-D1 overexpression
Tx: Surgery if pt has sx or if <50 yo c inc Ca2+ and dec T score
Secondary hyperparathyroidism
- aka (Primary) Parathyroid hyperplasia (?)
Primarily a Ca2+ disorder, 2/2 CKD causing hypervitaminosis D and dec Ca2+ absorption in gut and inc PO4-
Labs: hypocalcemia, hyperphosphatemia, inc alk phos, inc PTH
Clinically, all 4 glands will be hypertrophic and enlarged, and there will be inc intraglandular / intracellular fat microscopically (>50%?)
- can be up to 70 grams, usually 2/2 chief cell hyperplasia (water-cell hyperplasia less common)
- bc hyperplasia is a systemic dz, hyperplasia will recur if only 1 parathyroid gland is removed
-- hyperplasia may begin in 1 gland and then continue to other glands, thus mimicking an adenoma
Tertiary Hyperparathyroidism
Autonomous parathyroid hyperfunction
- hyperplasia persists even after stimulus removed
- usually in pts c chronic renal dz
Hypoparathyroidism
2/2 accidental surgical excision, DiGeorge syndrome or autoimmune disease
Sx: tetany, hypocalcemia, Chvotek's sign (tap facial nerve), Trousseau's sign (tapping brachial artery)
Pseudohypoparathyroidism
- aka Albright's hereditary osteodystrophy
AD disease in which kidney unresponsive to PTH
Sx: hypocalcemia, short 4th/5th digits, short stature
Parathyroid Carcinoma
Up to 2% of pts c hyperparathyroidism, M=F, ~50 yo, inc Ca2+, neck mass
- 1/3 have LN mets and 1/3 c distant mets at presentation
Micro: trabecular, thick fibrous bands, capsular invasion, mits, but need to see invasion into surrounding tissue or distant mets
IHC: (+) Cam5.2, AE1/AE3, PTH, CD56, SYN, CHR
- neg: TTF-1, thyroglobulin, PAX8, parafibromin
Genes: mutations in HRPT2/CDC73 gene on chr 1 which encodes parafibromin
- same gene is mutated in hyperparathyroidism-jaw tumor (HPT-JT) syndrome, which has ossifying fibromas of the jaw, uterine and renal tumors and parathyroid tumors
- PRAD 1, MEN 1, Cyclin D1 overexpression
Tx: surgery


Parathyroid adenoma


Parathyroid adenoma with rim of normal parathyroid tissue and small b9 cyst

Parathyroid carcinoma

References
1. Zhang, L. A Pilot Study of Galectin-3, HMBE-1, and p27 Triple Immunostaining Pattern for Diagnosis of Indeterminate Thyroid Nodules in Cytology with Correlation in Histology. Appl IHC Mol Morpholl 23,7, Aigist 2015
2. Seethala et al. Noninvasive follicular thyroid neoplasm with papillary-like nuclear features: a review for pathologists. Modern Pathology (2018) 31, 39–55; doi:10.1038/modpathol.2017.130; published online 20 October 2017
3.
